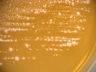

Accessioned in 1992.
Lactobacillus farraginis.
Lactobacillus reuteri.
Medium: 1; Temperature: 30°C; Rehydration fluid: 663.

open link in new window

open link in new window
|
8605 <-- M. Seki M31 <-- S. Tanasupawat. Accessioned in 1992. Lactobacillus farraginis. Lactobacillus reuteri. Medium: 1; Temperature: 30°C; Rehydration fluid: 663. |
open link in new window |
 open link in new window |
| Biosafety level | 1 | |
| Terms and conditions | Not applicable | |
| Export control (1) | No | |
| Distribution control in Japan (2) | No | |
| Genetically modified microorganism | No | |
| Technical information | - | |
| Additional information | - | |
| Domestic | A (Freeze-dried or L-dried culture) or C (Actively growing culture on request) | |
| Overseas | A (Freeze-dried or L-dried culture) or C (Actively growing culture on request) |
 Instructions for an order
Instructions for an order
 Go to JCM Top Page
Go to JCM Top Page
 Go to List of JCM strains
Go to List of JCM strains